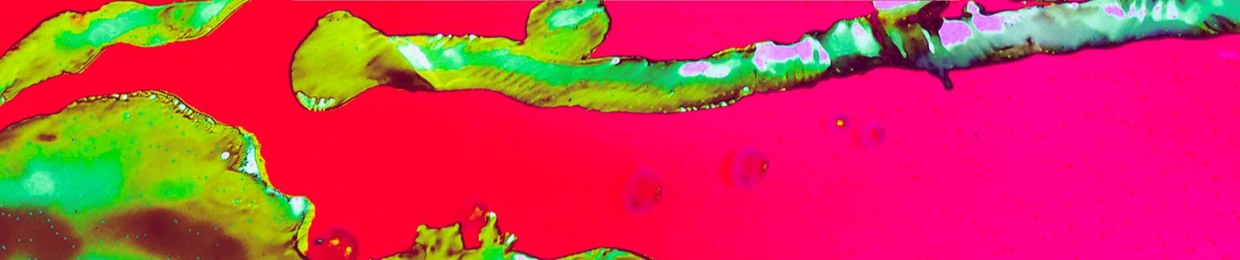
Petit Tambour

Petit Tambour
--------------
Petit Tambour
--------------
Petit Tambour is
a young sound project from switzerland.
Influenced by coldwave, lofi, indie music,
post-punk, minimal synth, french pop...

--------------
Petit Tambour
--------------
Petit Tambour is
a young sound project from switzerland.
Influenced by coldwave, lofi, indie music,
post-punk, minimal synth, french pop...